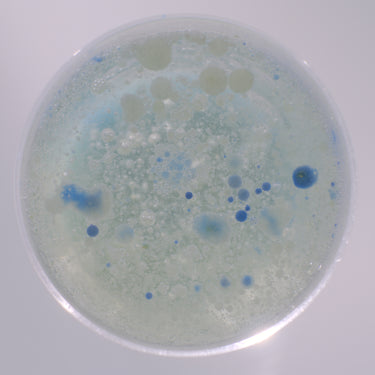
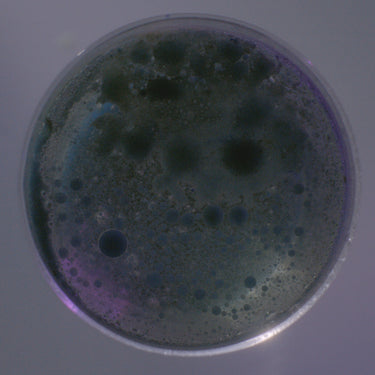
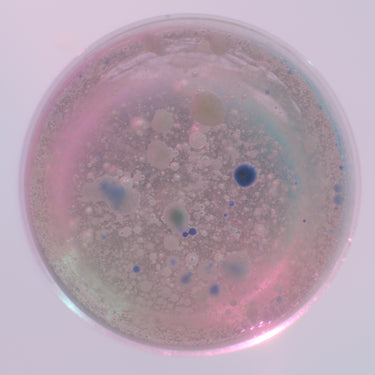
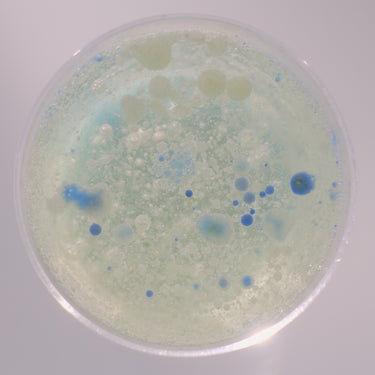

Formulated with purpose,
designed for impact.
We only use “clean” ingredients that are essential to a formula’s performance, never more and never less. Each ingredient has a purpose — one that we’ve defined in language that doesn’t require a chemistry degree to understand.
Explore our ingredients below.

A gentle surfactant derived from canola oil; used here to smooth and nourish your hair.

A plant oil derived from the kernels, meat, and milk of the coconut palm and fruit.

A soft, fibrous substance often used for textiles.

Our hand sanitizer formula consists of 65% alcohol, meeting CDC recommendations.

Obtained from ripe olive fruits; this oil's high content of monounsaturated fat makes it a nourishing ingredient.
Plant extract from the leaves of the Camellia oleifera, a type of green tea, with antioxidant properties.

A sugar found naturally in our skin that holds water and helps keep it hydrated.

Derived from the seeds of Morigna Oleifera — this oil helps hair look shinier and smoother.
Oil from the seed of Brassica rapa plants containing emollient and antioxidant properties for the skin.

A conditioning agent for our skin and hair.
A nut butter comprised of saturated and unsaturated fatty acids — full of vitamins A, E, F, and Carotene.

A naturally occurring element that prevents tooth decay.

A gentle plant-based cleansing and foaming agent.

This is a wax that gives the deodorant stick structure.

A moisturizing oil derived from the sunflower plant that makes our body wash smoother and more spreadable.

We infused our floss with vegetable wax for easy gliding between teeth.